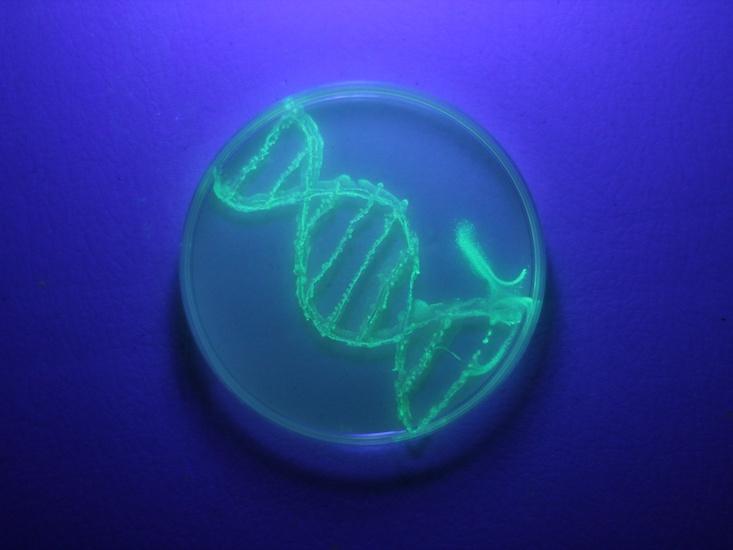
Kozubek-DNA-editing_HERO

Gene editing
1 articles-
Gene Editing Must Reckon With the Unforeseen
Almost exactly a year ago, I attended the International Summit of Human Gene Editing at the National Academy of Sciences. It was organized in part by Jennifer Doudna, arguably one of the inventors of Crispr-Cas9. It’s a new biotech tool—cheap, easy to use, and reliable—that allows thousands of scientists around the world to modify genes […]